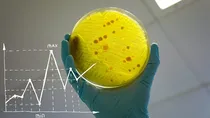
antibiotic

एंटीबायोटिक्स अगले 25 साल में हो सकती हैं बेअसर! रेजिस्टेंस के चलते 3.9 करोड़ जिंदगियां खतरे में!
Health and Antibiotic: हाल ही में मेडिकल जर्नल लैंसेट में एक रिसर्च आई है. जो Antibiotic के खिलाफ प्रतिरोधक हो रहे, बैक्टीरिया वगैरह पर चिंता जता रही है.
एंटी-बायोटिक (Antibiotics) यानी बैक्टीरिया वगैरह को खत्म करने वाली दवाएं. इनका इस्तेमाल लगभग सबने कभी ना कभी किया ही है. लेकिन जरूरत से ज्यादा या गलत इस्तेमाल के चलते, एंटीबॉयोटिक रेजिस्टेंस हो सकता है. यानी बैक्टीरिया इसके खिलाफ प्रतिरोधक क्षमता पैदा कर सकते हैं. और इसका असर उन पर कम हो सकता है. अब एक हालिया रिसर्च बता रही है. कि एंटी-बॉयोटिक रेजिस्टेंस के चलते, साल 1990-2021 के बीच हर साल 10 लाख से भी ज्यादा लोगों ने अपनी जान गंवाई.
रिसर्च जर्नल लैंसेट (Lancet) में छपी ये स्टडी, इसका दावा कर रही है कि एंटी-बॉयोटिक रेजिस्टेंस के चलते साल 2050 तक, करीब 3 करोड़ 90 लाख लोग अपनी जान गंवा सकते हैं. दरअसल एंटी-बॉयोटिक का काम हमारे शरीर के बैक्टीरिया को मारने का है. लेकिन अगर इनका इस्तेमाल सही तरीके से ना किया जाए, तो बैक्टीरिया पर इसका असर कम हो सकता है. जिसके चलते हमारे शरीर पर बैक्टीरिया वगैरह के हमले से बचाने में, एंटी-बॉयोटिक असमर्थ हो सकती हैं.
वहीं PTI की रिपोर्ट के मुताबिक स्टडी में ये भी बताया गया कि दक्षिण एशियाई देशों में - इसका ज्यादा असर देखने मिल सकता है. जिसमें भारत, पाकिस्तान और बांग्लादेश जैसे देश शामिल हैं. जहां एंटी-बॉयोटिक रेजिस्टेंस से सीधे जुड़ी मौतों की संख्या करीब 1 करोड़ 18 लाख, होने की आशंका जताई जा रही है.
साल 1990 और 2021 के बीच क्या हाल रहा?बताया जा रहा है कि साल 1990 से लेकर 2021 के बीच, 70 से ज्यादा साल के लोगों में एंटी-बॉयोटिक रेजिस्टेंस के चलते मरने वालों की संख्या - 80 फीसदी से ज्यादा दर से बढ़ी है. आशंका जताई जा रही है कि आने वाले सालों में बुजुर्ग इसके सबसे ज्यादा शिकार हो सकते हैं.
हालांकि इन्हीं सालों के बीच, पांच साल से कम उम्र के बच्चों में इसके चलते होने वाली मौतों में - 50 फीसदी की गिरावट भी देखी गई है.
ये भी पढ़ें: आंखों की जांच के टाइम ये तस्वीरें जरूर देखी होंगी, इनका 'असली काम' अब पता चला है!
रिसर्च से जुड़े, इंस्टीट्यूट ऑफ हेल्थ मैट्रिक्स - यूनिवर्सिटी ऑफ वाशिंगटन के प्रोफेसर केविन इकुटा बताते हैं,
बच्चों में पिछले तीन दशकों में, सेप्सिस (एक तरह का खून का इंफेक्शन) और एंटी-बॉयोटिक रेजिस्टेंस के चलते होने वाली मौतों में गिरावट एक मिसाल है. हालांकि ये फाइंडिंग्स ये भी बताती हैं कि बच्चों में होने वाले इंफेक्शन कम तो हुए हैं. लेकिन जब होते हैं, तो उनका इलाज करना और मुश्किल भी हुआ है.
साथ ही ये अनुमान भी लगाया गया है कि साल 2025 से लेकर 2050 के बीच में, अगर बेहतर स्वास्थ्य सेवाओं और एंटीबॉयोटिक दवाओं को मुहैया करवाया जाए, तो 9.2 करोड़ लोगों की जिंदगियों को बचाया भी जा सकता है.
वीडियो: सेहत: एंटीबायोटिक मेडिसिन यानी दवाई खाते वक़्त ये गलतियां भूलकर भी न करें

